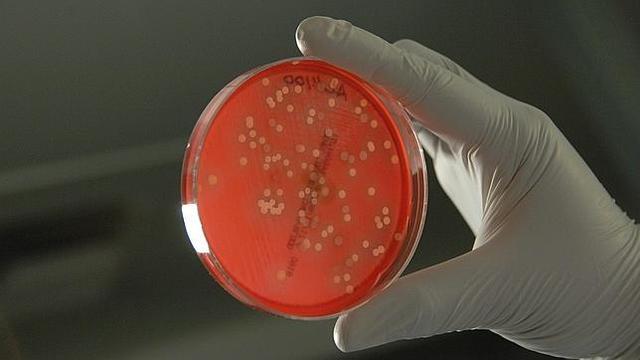
Estudio de bacterias.

-
El genoma se privatiza y la empresa Celera anuncia que pretende para el 2001 tener el genoma humano descifrado.
-
Primer mamífero clónico
-
Comienza el proyecto Genoma Humano
-
James Watson y Francis Crick descubridores de como esta hecha el ADN
-
Estudio de bacterias muestra que los genes están formados por ADN , se encuentran en el núcleo de las células
-
Monje austriaco , que describe las leyes básicas de la genética después del estudio de los guisantes .
Su obra no es reconocida hasta principios del siglo XX. -
Se generalizan los cultivos de plantas transgenicas
-
Descubren cómo cortar y pegar el ADN .
Angel Pellicer, científico ESPAÑOL que obtuvo un papel importante en ESTADOS UNIDOS -
Científicos encuentran genes que causan enfermedades.
El cáncer es una de ellas y los científicos españoles son dos de los pioneros, Mariano Barbacid y Manuel Perucho -
Realización de experimentos con moscas del vinagre muestran que los genes los tenemos en los cromosomas.
Want to make a timeline like this?
Use Timetoast to turn dates, events, milestones, and phases into a clear visual timeline you can build and share. Timetoast is a timeline maker for work, school, research, and stories.